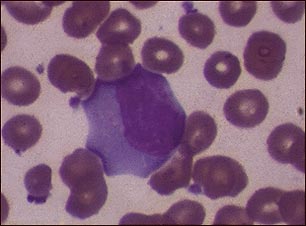
Mononucleosis infecciosa #3

![]() | ![]() | ![]() |
Mononucleosis infecciosa #3
El virus de Epstein-Barr es el causante de la mononucleosis infecciosa, infección viral que provoca temperaturas altas, dolor de garganta e hinchazón de los ganglios linfáticos. La mononucleosis infecciosa puede ser contagiosa si la persona infectada tiene contacto cercano o íntimo con otra, ya sea de naturaleza sexual o a través de la saliva.
Actualizado: 9/17/2008
